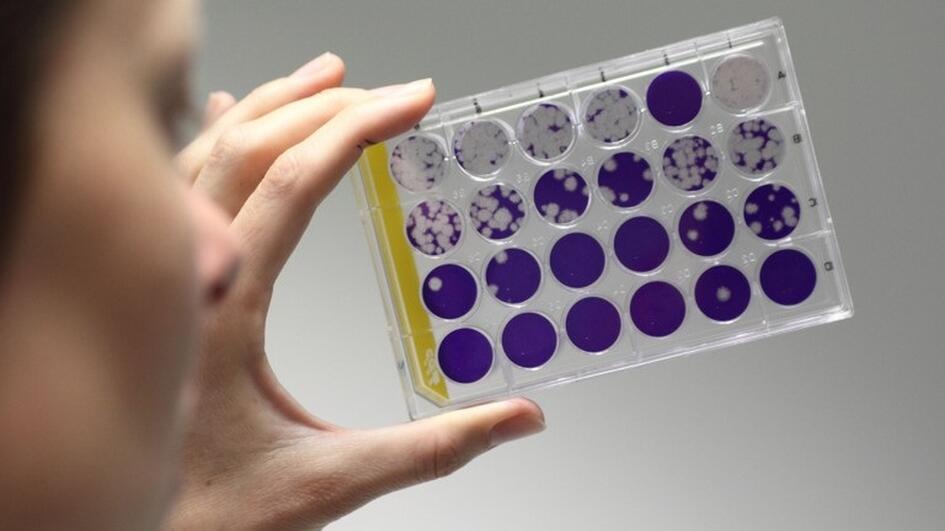

Covid 19 Antikoerpertest Berlin


Coronavirus Rush To Develop Rapid Tests Business Economy And Finance News From A German Perspective Dw 28 03 2020
www.dw.com

German Virologists Say People Initially Immune After Coronavirus Infection The Local
www.thelocal.de

Euroimmun Now Offers A Complete Test Package For Direct Detection Of The New Coronavirus And Antibodies Against Sars Cov 2 Euroimmunblog
www.euroimmunblog.com

Coronavirus Virological Findings From Patients Treated In A Munich Hospital Charite Universitatsmedizin Berlin
www.charite.de